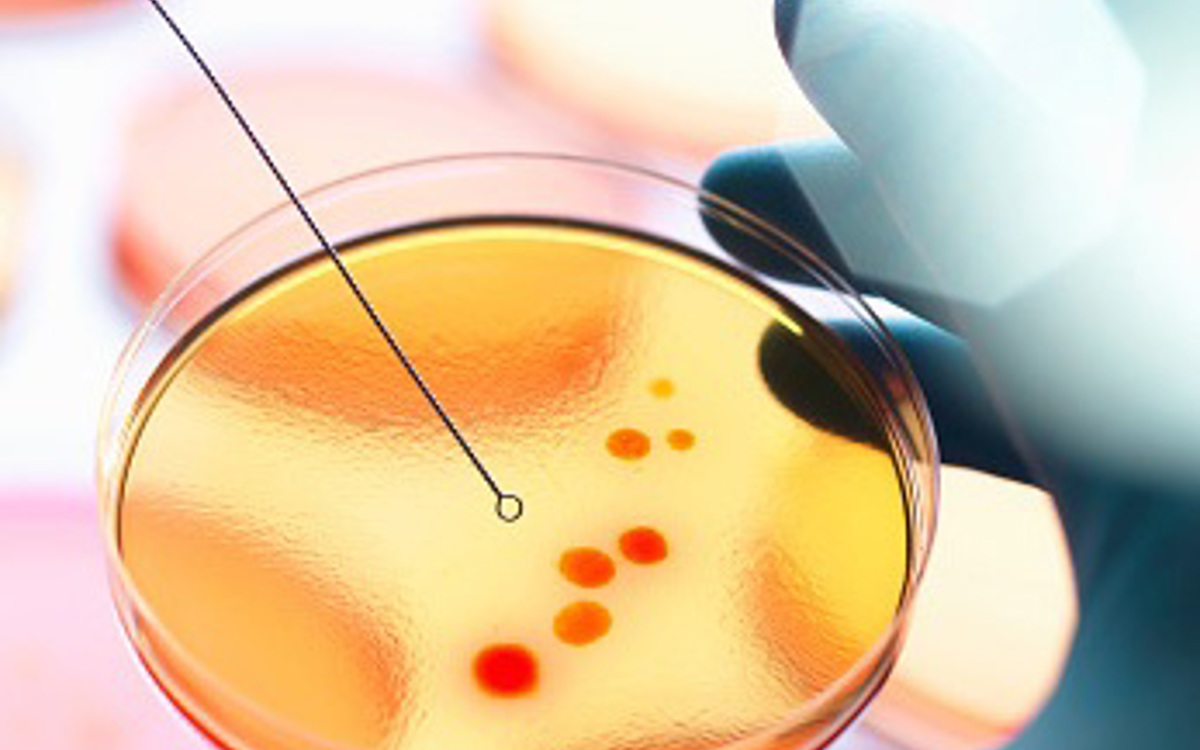

Committees, Boards and Groups
As an ESE Member, you can make a difference by becoming a member of one of our Committees or Boards or Groups and help fulfil our vision to unite, support and represent the endocrine community.
Make a a difference by becoming a member of one of our Committees and help fulfill our vision to unite, support and represent the endocrine community!
Each of our Committee Members are requested to declare their conflict of interests, if you would like further information please contact the ESE Office >>
The European Society of Endocrinology (ESE) is at the centre of Europe's endocrine community. Together we work to develop knowledge and share expertise in endocrine science and medicine.
You can make a difference by becoming a member of one of our Committees and help fulfill our vision to unite, support and represent the endocrine community. Committee members must be current members of ESE.

ESE supports endocrine professionals in different roles and career stages to collaborate, learn and stay up to date with the latest advances in the field.
Explore upcoming training opportunities, grants and resources tailored to your community below.